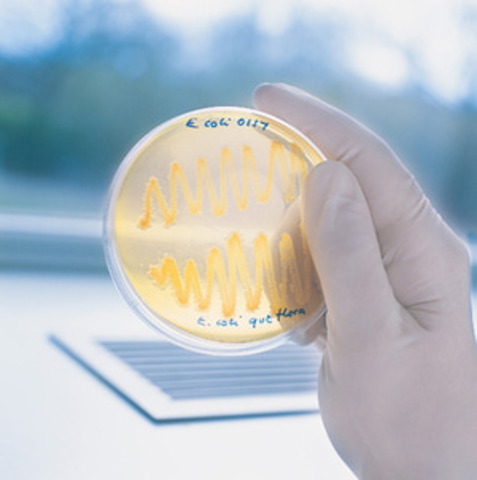
Microbiology

-
The first small pox vaccination was invented by Edward Jenner.
-
Louis Pasteur invented the germ theory of disease.
-
Christian Gram invented the gram stain, a staining method for the classification of bacteria.
-
Jonas Salk invented the Polio vaccine.
-
Andrew J Moyer was granted a patent for a method of the mass production of penicillin.
-
Becton, Dickinson and Company created the first mass-produced disposable syringe and needle, produced in glass.
-
Benjamin A. Rubin invented a pronged vaccination needle used for smallpox vaccinations.
-
W. Gilbert & F. Sanger invented a method to sequence DNA
-
Kary Mullis invented the polymerase chain reaction
-
The first microbial genomic sequence H. influenzae was published by Craig Venter, Hamilton Smith, Claire Fraser, and colleagues at TIGR.
A list shows items. A timeline shows sequence.
Use Timetoast to make dates, milestones, and turning points easier to understand in a clear visual format. Timetoast is a timeline maker for work, school, research, and stories.